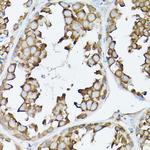
GARS Antibody in Immunohistochemistry (Paraffin) (IHC (P))

Search
Invitrogen
GARS Polyclonal Antibody
{{$productOrderCtrl.translations['antibody.pdp.commerceCard.promotion.promotions']}}
{{$productOrderCtrl.translations['antibody.pdp.commerceCard.promotion.viewpromo']}}
{{$productOrderCtrl.translations['antibody.pdp.commerceCard.promotion.promocode']}}: {{promo.promoCode}} {{promo.promoTitle}} {{promo.promoDescription}}. {{$productOrderCtrl.translations['antibody.pdp.commerceCard.promotion.learnmore']}}

Please note: We are reviewing Western blot images included in the antibody testing data in our catalog, including those provided by third parties. Unless expressly labeled or annotated as “raw-unedited”, Western blot images included in the antibody testing data in our catalog may have been edited, optimized or otherwise adjusted for presentation.
产品信息
PA5-96322
种属反应
宿主/亚型
分类
类型
抗原
偶联物
形式
浓度
规格
纯化类型
保存液
内含物
保存条件
运输条件
RRID
产品详细信息
Immunogen sequence: AEEVLAPLRL AVRQQGDLVR KLKEDKAPQV DVDKAVAELK ARKRVLEAKE LALQPKDDIV DRAKMEDTLK RRFFYDQAFA IYGGVSGLYD FGPVGCALKN NIIQTWRQHF IQEEQILEID CTMLTPEPVL KTSGHVDKFA DFMVKDVKNG ECFRADHLLK AHLQKLMSDK KCSVEKKSEM ESVLAQLDNY GQQELADLFV NYNVKSPITG NDLSPPVSFN LMFKTFIGPG GNMPGYLRPE TAQGIFLNFK RLLEFNQGKL PFAAAQIGNS FRNEISPRSG LIRVREFTMA EIEHFVDPSE KDHPKFQNVA D; Positive Samples: Jurkat, 293T, U-87MG, Raji, M21, HT-29, Mouse brain, Mouse spinal cord; Cellular Location: Cell projection, Cytoplasm, Mitochondrion, axon
靶标信息
GARS is a glycyl-tRNA synthetase, one of the aminoacyl-tRNA synthetases that charge tRNAs with their cognate amino acids. This protein is an (alpha)2 dimer which belongs to the class II family of tRNA synthetases. The protein has been shown to be a target of autoantibodies in the human autoimmune diseases, polymyositis or dermatomyositis.
仅用于科研。不用于诊断过程。未经明确授权不得转售。
篇参考文献 (0)
生物信息学
蛋白别名: 6.1.1.14; AIR synthase; AIRS; AP-4-A synthetase; Ap4A synthetase; Charcot-Marie-Tooth neuropathy 2D; Charcot-Marie-Tooth neuropathy, neuronal type, D; Diadenosine tetraphosphate synthetase; EC 2.1.2.29; GAR transformylase; GART; GARTF; Glycine--tRNA ligase; Glycyl-tRNA synthetase; Glycyl-tRNA synthetase 1; GlyRS; MGC47764; PAIS; PGFT; PRGS; storage granule protein 23; unnamed protein product
基因别名: CMT2D; DSMAV; GARS; GARS1; Gena201; GENA202; GlyRS; HMN5; HMN5A; HMND5; Nmf249; RGD1559871; Sgrp23; SMAD1; SMAJI
UniProt ID: (Rat) Q5I0G4, (Mouse) Q9CZD3
Entrez Gene ID: (Human) 2617, (Rat) 297113, (Mouse) 353172




